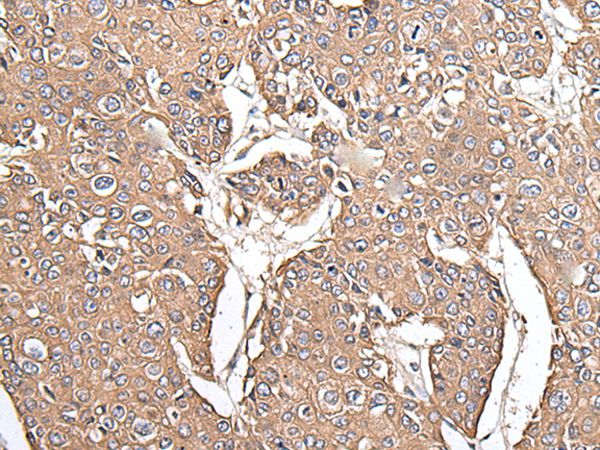

KRT73 / Keratin 73 Antibody (C-Terminus)
LS-C170489
ApplicationsWestern Blot
Product group Antibodies
TargetKRT73
Overview
- SupplierLifeSpan BioSciences
- Product NameKRT73 / Keratin 73 Antibody (C-Terminus)
- Delivery Days Customer14
- ApplicationsWestern Blot
- Applications SupplierWB
- CertificationResearch Use Only
- ClonalityPolyclonal
- Concentration0.5 mg/ml
- ConjugateUnconjugated
- Estimated Purity...
- Gene ID319101
- Target nameKRT73
- Target descriptionkeratin 73
- Target synonymsCK-73; cytokeratin-73; IRT6IRS3; K6IRS3; K73; keratin 6 irs3; keratin 73, type II; keratin, type II cytoskeletal 73; KRT6IRS3; type II inner root sheath-specific keratin-K6irs3; type-II keratin Kb36
- HostRabbit
- Storage Instruction-20°C,2°C to 8°C
- UNSPSC12352203